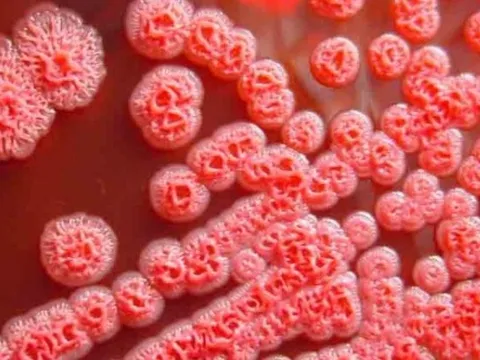
Những biểu hiện lâm sàng thường gặp của bệnh Whitmore

Y tế - Sức khỏe
4 thói quen khiến nam giới 'đoản mệnh': Nếu bạn đang có thì nên thay đổi ngay
Theo các chuyên gia dưỡng sinh, có rất nhiều yếu tố trong cuộc sống có thể ảnh hưởng đến tuổi thọ của một người đàn ông, đây là đặc điểm của người có tuổi thọ ngắn.
Khám 'nội thất' trước ngày lên xe hoa
Cách đây 30 năm, một thanh niên đã phản ứng khá mạnh khi bị “nhạc phụ đại nhân tương lai” yêu cầu đi khám sức khỏe và lấy kết quả xét nghiệm, rồi hẵng tính đến chuyện cưới hỏi.
Trẻ mắc hội chứng TIC nhiều hơn sau dịch COVID-19
Các bác sĩ cho biết sau đợt dịch COVID-19 tỉ lệ trẻ mắc phải hội chứng TIC có xu hướng gia tăng gây ảnh hưởng đến tâm lý, kết quả học tập của trẻ.
Phạt nặng 2 công ty dược ở TP HCM vi phạm trong sản xuất thuốc
Ngoài số phạt tiền 230 triệu đồng do vi phạm sản xuất thuốc, cơ quan quản lý buộc hai công ty dược tiêu hủy lô thuốc kém chất lượng và thuốc sản xuất từ nguyên liệu hết hạn.
Vì sao số người bệnh tiểu đường tăng chóng mặt?
Theo thống kê, dân số thế giới hiện tăng khoảng 20%, nhưng số người mắc bệnh tiểu đường lại tăng đến 46%.
Vụ bệnh nhân chạy thận lúc nửa đêm: Bố trí 2,4 tỉ đồng sửa máy
Tỉnh Bà Rịa - Vũng Tàu đã họp và thống nhất chi hơn 2,4 tỉ đồng để sửa chữa hàng loạt máy lọc máu đang hỏng tại Bệnh viện Bà Rịa.
50% số ca ung thư tử vong vì phát hiện 'quá muộn': 10 dấu hiệu không nên bỏ qua
Theo Dịch vụ Y tế Quốc gia (Anh), hơn một nửa số ca ung thư tuyến tụy đang được chẩn đoán trong trường hợp khẩn cấp, cơ hội sống sót thấp hơn rất nhiều.
Sai lầm trong việc chẩn đoán, điều trị cúm B
Năm nay, cúm B có xu hướng lan rộng và xuất hiện nhiều trường hợp biến chứng nặng. Nhiều phụ huynh gặp phải những sai lầm trong việc tự điều trị bệnh cho con.
Bị tôn trên xe ba gác cắt trúng cổ, người đàn ông suýt chết
Xảy ra va chạm giao thông với xe ba gác, người đàn ông ở tỉnh Quảng Nam bị tấm tôn trên xe cắt vào phần cổ suýt mất mạng.
Hà Nội: Thêm 1 người tử vong sau 2 tháng bị chó cắn
Theo thông tin từ Trung tâm Kiểm soát bệnh tật (CDC) Hà Nội, một nam bệnh nhân, 45 tuổi, vừa tử vong do mắc bệnh dại sau 2 tháng bị chó cắn vào tay.
5 thói quen tốt giúp kéo dài hơn 10 năm tuổi thọ: Nên áp dụng ngay từ bây giờ
Nghiên cứu cho thấy, một vài thay đổi về chế độ ăn uống có thể kéo dài tuổi thọ của bạn đến 10 năm trong cuộc đời.
Những biểu hiện lâm sàng thường gặp của bệnh Whitmore
Whitmore là bệnh nhiễm trùng ở người và động vật do vi khuẩn Burkholderia pseudomallei gây ra.
Đột phá trong chữa trị ung thư bằng công nghệ chỉnh sửa gene
Các nhà khoa học đã thành công chỉnh sửa gene tế bào miễn dịch của một số bệnh nhân qua công nghệ CRISPR, điều hướng chúng tấn công các khối u trong cơ thể.
Biến chứng từ cúm mùa có thể dẫn đến tử vong
Hiện nhiều người có tâm lý chủ quan với bệnh này nhưng biến chứng từ cúm mùa rất nguy hiểm.